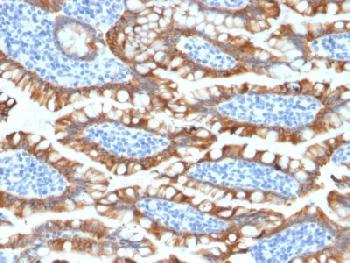

Anti-Cytokeratin 8 (KRT8) Recombinant Rabbit Monoclonal Antibody (Clone:KRT8/2174R)
Figure 1: Formalin-fixed, paraffin-embedded human Small Intestine stained with Cytokeratin 8 Rabbit Recombinant Monoclonal Antibody (KRT8/2174R).
Roll over image to zoom in
Shipping Info:
For estimated delivery dates, please contact us at [email protected]
Format : | Purified |
Amount : | 100 µg |
Isotype : | Rabbit IgG |
Purification : | Protein A/G |
Content : | 200µg/ml of recombinant MAb purified by Protein A/G. Prepared in 10mM PBS with 0.05% BSA & 0.05% azide. Also available WITHOUT BSA & azide at 1.0mg/ml. |
Storage condition : | Antibody with azide - store at 2 to 8°C. Antibody without azide - store at -20 to -80°C. Antibody is stable for 24 months. Non-hazardous. |
Cytokeratin 8 (CK8) belongs to the type II (or B or basic) subfamily of high molecular weight cytokeratins and exists in combination with cytokeratin 18 (CK18). CK8 is primarily found in the non-squamous epithelia and is present in majority of adenocarcinomas and ductal carcinomas. It is absent in squamous cell carcinomas. Hepatocellular carcinomas are defined by the use of antibodies that recognize only cytokeratin 8 and 18. CK8 exists on several types of normal and neoplastic epithelia, including many ductal and glandular epithelia such as colon, stomach, small intestine, trachea, and esophagus as well as in transitional epithelium. Anti-CK8 does not react with skeletal muscle or nerve cells. Epithelioid sarcoma, chordoma, and adamantinoma show strong positivity corresponding to that of simple epithelia (with antibodies against CK8, CK18 and CK19). Reportedly, anti-CK8 is useful for the differentiation of lobular ( ring-like, perinuclear ) from ductal ( peripheral-predominant ) carcinoma of the breast.
Western Blot (1-2µg/ml); Immunohistochemistry (Formalin-fixed) (1-2µg/ml for 30 min at RT)(Staining of formalin-fixed tissues is enhanced by heating tissue sections in 10mM Tris with 1mM EDTA, pH 9.0 for 45 min at 95°C followed by cooling at RT for 20 minutes)
For Research Use Only. Not for use in diagnostic/therapeutics procedures.
Subcellular location: | Cytoplasm, Nucleus, Nucleus matrix |
Post transnational modification: | O-glycosylated (O-GlcNAcylated), in a cell cycle-dependent manner. |
Tissue Specificity: | Observed in muscle fibers accumulating in the costameres of myoplasm at the sarcolemma membrane in structures that contain dystrophin and spectrin. Expressed in gingival mucosa and hard palate of the oral cavity. |
BioGrid: | 110054. 69 interactions. |
There are currently no product reviews
|